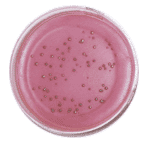

Holen Sie sich gesundes Wasser in's Haus! Wasser ist erweiterte Heilung!
Was "Wellan" noch kann!Wasser ist Leben - Wasser schafft Leben - aus dem Wasser kommt Leben!
| 2 Drittel der Erdoberfläche besteht aus Wasser, aus 2 Dritteln Wasser besteht unser menschlicher Körper! Das Element Wasser ist für den Menschen das wichtigste Nahrungsmittel. Wasser ist Energie und Informationsträger. Das Wissen um die Speicherfähigkeit des Wassers ist von höchster Bedeutung - leider sind die physikalischen Vor- gänge der Informationsaufnahme, Speicherung und Informationsabgabe, wissenschaftlich noch nicht gesichert. Wahrscheinlich erfolgt die Auf- nahme letzterer, über bestimmte Frequenzen, mit welchen das Wasser feinste elektromagnetische Felder produziert die von Wassermolekül zu Wassermolekül in Bruchteil von Sekunden weiter- gegeben werden. |
![]() |
Die Aufgaben des Wassers im menschlichen Körper sind vielfältig: alle Aufgaben des Wassers in
unserem Körper zu nennen würde den Rahmen dieser Ausführung sprengen, dennoch möchten wir nicht
versäumen die wichtigsten anzuführen.
- Regulierung des Wasserhaushaltes
- Die Versorgung aller Zellen und Gewebe mit Wasser in der richtigen Quantität und
- Qualität.
- Regulierung des osmotischen Druckes der Flüssigkeitsräume.
- Mitwirkung bei der Regulierung des Energiehaushaltes.
- Mitwirkung bei der Regulierung des Elektrolythaushaltes.
- Funktion als Energieträger ( Wasser als hochsensitiver Speicher für elektromagnetische
Felder.)
- Funktion als Informationsträger ( lässt alle Teile des Körpers miteinander
kommunizieren.)
- Mitwirkung bei der Regulierung des Basen Säuregehaltes.
- Mitwirken als Reaktionsmittel für chemische Prozesse.
- Wirkung als Lösungsmittel.
- Reinigung des Körpers ( Entgiftung )
- Wirkung als Transportmittel.
- Mitwirkung bei Temperaturregelung
- Wirkung als Füllstoff und Puffersystem.
- Wirkung als Heilmittel!!!
So wird dem Wasser eine entgiftende Funktion zugestanden, an dieser Stelle,
sollten wir uns an die vielen Wasserkuren, wie Kneippkuren, Trinkkuren, Waschungen,
Aufgüsse, Dampfbäder, Saunabäder usw. erinnern.
In diesem Zusammenhang, unterscheiden wir zwei verschiedene
Belastungen des Wassers:
A - Die substanzielle Verunreinigung des Wassers.
B - Die informative Verunreinigung des Wassers.
Grundsätzlich ist zu sagen, dass das Wasserwerk nur Wasser anbietet welches den Trinkwasserverordnungen
entspricht. Es ist optisch rein, reiner Geschmack, keimfrei. Wenn das Wasser aber in unseren Haushalt gelangt,
hat es bereits kilometerlange Rohre durchflossen, elektromagnetische Felder passiert usw., d.h.
Die Wasserqualität hat sich verschlechtert. Das Wasser hat Metalle als Ionen aufgenommen, z.B. Zink,
Kupfer, Blei, um nur einige zu nennen, welche in hoher Konzentration gesundheitliche Schäden verursachen können.
Des weiteren können sich Keime gebildet haben, Legionellen, ( sitzen als Nester im abgelagerten Kalk und können bei
immun geschwächten Menschen zum Tode führen.
E-Coli Bakterien, können schlimmste Infektionen verursachen, Pseudonoma airogunosa, ist ein Bodenbakterium
welches auch häufig im Wasser vorkommt und gesundheitliche Schäden verursachen können.
Im Haushalt bringen wir Waschmittel Putzmittel und andere Haushaltschemikalien in unser Wasser.
Das Wasser wird belastet. Diese Stoffe werden jedoch über die Kläranlage mit aufwendigen chemischen
Prozessen entfernt, es sollte jedoch nicht vergessen werden, wie aufgeführt, dass das Wasser als
Informationsspeicher fungiert und somit energetische Frequenzen -Informationen, dieser Stoffe speichern kann.
Jede chemische Substanz hinterlässt im Wasser einen informativen Fingerabdruck, welcher unter normalen Umständen
nicht aufgehoben wird und auf lange Sicht in unserem Körperwasser weiter wirkt.
Dazu gesellen sich Wohngifte, Elektrosmog, Autoabgase und deren mehr. Folgen: immer mehr Allergiker -
MCS Kranke - Rheuma Kranke - Krebskranke und andere...
" Wellan " hilft!
"Wellan" - Wasser gibt dem Wasser wieder neue Energien
( in Bovis-Einheiten gemessen ) s. Untersuchungsbericht.
"Wellan" - Wasser entgiftet den Körper, macht das Wasser reiner
( Senkung des Leitwertes ) s. Untersuchungsbericht.
"Wellan"- verbessert die Trinkwasserqualität
( s. Untersuchungsbericht Institut Hagalis )
"Wellan" - macht Bakterien unschädlich
( s. Untersuchungsbericht - Umwelt und Hygiene Institut Dr. Prucha.
"Wellan" - verhindert Algen- und Fäulnisbildung
( s. Referenz Schwimmbäder in Spanien ).
Nur heiles Wasser kann heilen!!!
Kristallanalyse
Auszug aus Gutachten WELLAN 2000 ®
Hagalis Assoziation
Vergleichsstudie: Wasseraufbereitungssysteme
Auswertung
Untersuchte Proben:
Wasserprobe: WELLAN 2000 ®, zweite Probe
Innerhalb einer Vergleichsstudie, bei der insgesamt 2 Proben gezogen wurden, von denen hier 2 zur
vergleichenden Auswertung kamen, wurde das spagyrische Kristallisat untersucht, welches aus der
Flüssigphase und der Festphase der Proben gewonnen wurde.
Die Kristalle entstehen dabei aus der Extraktion des Destillatrückstandes, der zuvor verascht und
ealciniert wurde. Diese Kristallsalze werden mit dem Destillat vereinigt und auf Objektträger aufgebracht.
Die Flüssigkeit wird bei Raumtemperatur zur Verdunstung gebracht. Dabei entstehen den Proben typisch zugeordnete
Kristallbilder, die eine Aussage über die Qualität der Lebenskräfte der Proben erlauben.
Herstellung des Kristallisates im Überblick:
1. Destillation der Probe ohne Zusätze von Wasser oder
sonstigen Lösungsmitteln bei niederen Temperaturen.
2. Gewinnung des Kristallsalzes aus dem Destillatrück-
stand durch Veraschung und Calcination
3. Vereinigung von Destillat und Kristallsalzen und
anschließende Aufbringung auf Objektträger.
4. Entstehung der typischen, den Proben zugehörigen Kristallbilder -
Die Kristallbilder sind aus derselben Probe jederzeit reproduzierbar und zeigen immer die den Proben
typisch zugehörigen Kristallbilder.
Zusammenfassung:
Bildvergleich mit Neutralprobe:

Probe: Wasserprobe:
WELLAN 2000 ®, zweite Probe
In direktem Vergleich zeigt sich ein starker Unterschied zwischen der Neutralprobe und der hier untersuchten
Probe mit WELLAN 2000 ®, zweite Probe. Die wesentlichen Vorteile zeigen sich vor allem in der Zunahme der
Vitalität und der Ordnungsstruktur; die sich belebend auf den Verbraucher auswirkt. Es hat vermutlich eine
Zunahme der chemischen Aktivität des Wassers stattgefunden, die noch in chemischen Analysen dokumentiert wird.
In jedem Falle stellt sich eine qualitative Verbesserung gegenüber der Neutralprobe dar, die für den Verbraucher
von Vorteil ist.
Um auf die medizinischen Wirkungen eingehen und um genauere Aussagen machen zu, können müßten allerdings
weitere Studien im Zusammenhang mit Blutkristallanalysen betrieben werden. Dies ist im Rahmen dieser Studie
leider nicht möglich.
Aftholderberg, den 13.03.O0
A. Schulz
(Untersuchungsleiter)
Auszug aus Gutachten Metum-Stic ®
Hagalis Assoziation
Kristallanalyse
Vergleichsstudie: Wasseraufbereitungssysteme
Auswertung
Untersuchte Proben:
Wasserprobe: Metum-Stic
Innerhalb einer Vergleichsstudie, bei der insgesamt 2 Proben gezogen wurden, von denen hier 2 zur
vergleichenden Auswertung kamen, wurde das spagyrische Kristallisat untersucht, welches aus der Flüssigphase
und der Festphase der Proben gewonnen wurde.
Die Kristalle entstehen dabei aus der Extraktion des Destillatrückstandes, der zuvor verascht und
ealciniert wurde. Diese Kristallsalze werden mit dem Destillat vereinigt und auf Objektträger aufgebracht.
Die Flüssigkeit wird bei Raumtemperatur zur Verdunstung gebracht. Dabei entstehen den Proben typisch zugeordnete
Kristallbilder, die eine Aussage über die Qualität der Lebenskräfte der Proben erlauben.
Herstellung des Kristallisates im Überblick:
1. Destillation der Probe ohne Zusätze von Wasser oder
sonstigen Lösungsmitteln bei niederen Temperaturen.
2. Gewinnung des Kristallsalzes aus dem Destillatrück-
stand durch Veraschung und Calcination
3. Vereinigung von Destillat und Kristallsalzen und
anschließende Aufbringung auf Objektträger.
4. Entstehung der typischen, den Proben zugehörigen Kristallbilder -
Die Kristallbilder sind aus derselben Probe jederzeit reproduzierbar und zeigen immer die den Proben
typisch zugehörigen Kristallbilder.
Zusammenfassung:
Bildvergleich mit der Neutralprobe:

Metum-Stic, 400 fach vergrößert | Neutral, 400 fach vergrößert
In direktem Vergleich zeigt sich ein deutlicher Qualitätsunterschied zwischen beiden Proben.
Die mit dem Energiestab behandelten, Probe zeigt starke Qualitätsvorsprünge gegenüber, der Neutralprobe.
Herausragend sind die 60¼ Winkelstrukturen in Form der sternförmigen. Kristalle, welche eine deutliche
Vitalisierung des Wassers nachweisen. Sowohl Stoffwechsel wie auch Herz/Kreislaufsystem, werden, durch
das Wasser im Zusammenhang mit der Behandlung durch den, Energiestab beim Verbraucher positiv angeregt.
Dies war bei der Neutralprobe- nicht der, Fall und daher rechtfertigt sich die qualitativ bessere Beurteilung.
Hinsichtlich der Ablagerungen von Mineralien bei technischen Geräten ist auch eine, leichte Verbesserung zu verzeichnen.
Um auf die medizinischen Wirkungen eingehen und um genauere Aussagen, machen zu können, müßten allerdings
weitere Studien in Zusammenhang mit Blutkristallanalysen betrieben werden, Dies ist im Rahmen dieser Studie
leider nicht möglich.
Aftholderberg, den 13.03.00
A. Schulz (Untersuchungsleiter)
Institut für Hygiene und Umwelt (IHU)
Überprüfung der antimikrobiellen Wirkung des „Wellan“-Wasserbehandlungssystems
Graphische Darstellung der zeitabhängigen Änderung der Ps. aeruginosa-
Konzentration bei den Versuchsansätzen im Kryostaten mit und ohne „Wellan“-Ring

rot: Versuchsansatz im Kryostat mit Wellan-Ring
blau: Versuchsansatz im Kryostat ohne Wellan-Ring
Untere Abbildung:
Bestimmung der Keimkonzentration an Escherichia coli
Bei dem Versuchsansatz im Kryostaten mit „Wellan“-Ring
![]() E. coli IHU - Sofortwert |
![]() E. coli IHU - 1 Stunde |
Auszug aus Gutachten WELLAN® 2000
vom Institut Dr. phil. J.-Michael Kohfink
Augsburg, 20.10.1997
Auftrag von: Wagner Umwelttechnik
Objekt: Trinkwasser-Aufbereitungsgerät WELLAN® 2000
Grund: Qualitätsbestimmung von verschiedenen Wässern
Untersuchungsergebnis
"energieangereichertes Wasser"
Durch die Energieanreicherung und dem molekularaufgelösten Kalk hat sich der Qualitätswert mit
dem WELLAN® 2000 Biosignal-Wasserbehandler gegenüber dem unbehandelten Wasser verbessert. Das behandelte
Wasser zeigt wieder "Leben". Durch die Energieanreicherung bekommt das behandelte Wasser eine aufgeladene
Rechtsdrehung (normales Leitungswasser ist linksdrehend). Im Wasser werden die durch Verschmutzungen, Gifte,
Schwermetalle, Radioaktivitäten usw. unterdrückten Ur-Informationen zu.m Teil wieder aktiviert, d.h. das
Wasser beginnt wieder zu leben.
Zur Messung wurde normales Trinkwasser aus der Hauswasserleitung entnommen. Der Meßwert des Trinkwassers
betrug 23 Impulse/sek. Nach dem direkten Durchfluß durch den WELLAN® 2000 Biosignal-Wasserbehandler erhöhte
sich der Wert auf 35 Impulse/sek. (+52%).
Die Radioaktiv-Messung mit verschiedenen Radioaktiv-Meßgeräten (Geiger-Müller-Zähler) ergab keine meßbaren
Veränderungen, d.h. dem Wasser wird die natürliche Radioaktivität nicht entzogen.
Die elektrische Widerstandsmessung ergab ein reproduzierbares Ergebnis. Der Wert des unbehandelten Wassers
lag bei 430 µS. Durch die Aktivierung mit dem WELLAN® 2000 Biosignal-Wasserbehandler veränderte sich der
Wert auf 380 gS (- 12%). Je niedriger der SiemensWert ist (pS), desto besser ist die Wasserqualität.
Die Wasserbehandlung mit dem WELLAN® 2000 Biosignal-Wasserbehandler hat keinen Einfluß auf den pH-Wert.
Der WELLAN® 2000 Biosignal-Wasserbehandler verändert den Kalk-Wert durch die molekulare Auflösung stark positiv.
Die radiästhetischen Messungen ergaben, daß das mit dem WELLAN® 2000 Biosignal-Wasserbehandler behandelte Wasser,
von 5.960 Bovis-Einheiten auf 18.250 Bovis-Einheiten ansteigt. Dieser Anstieg (+200%) zeugt von einem sehr
guten Wirkungsgrad.
Durch den WELLAN® 2000 Biosignal-Wasserbehandler wird eine sehr gute Trinkwasser-Qualität geschaffen.
Die mit diesem Gutachten ermittelten Werte beziehen sich auf den WELLAN® 2000 Biosignal-Wasserbehandler von
der Firma WELLAN® 2000 EUROPE GmbH.
Wasser ist Leben, aber nur wenn es lebt!
Wasser-Test Vergleichswerte
| Medium | Measured Test Value (fresh water) |
Fines Value (fresh water) |
| Normales Leitungswasser | 23 I/Sek. | 5.960 BE |
| Regenwasser | 25 I/Sek. | 11.000 BE |
| Überkinger Mineralwasser | 25 I/Sek. | 14.000 BE |
| Volvic Wasser | 28 I/Sek. | 13.800 BE |
| Umkehr-Osmose-Wasser | 31 I/Sek. | 16.500 BE |
| Himalaja-Experimentierwasser | 34 I/Sek. | 14.100 BE |
| nach Körbler | ||
| WELLAN® 2000 Wasser | 35 I/Sek. | 18.250 BE |
I/Sek . = Impulse pro Sekunde
BE - Bovis-Einheiten nach A. Bovis

Je höher die Meßimpulse und Bovis-Einheiten,
je reiner und energiereicher ist das Medium.
"Wasser ist ein Urelement der lebendigen Natur,
Wiege des Lebens und Mittelpunkt vor allem, was lebt"
Szent György
"Alle Lebensprozesse sind unmittelbar oder
mittelbar mit dem Wasser verbunden. Daher kommt dem Wasser in der Umweltproblematik eine besondere Stellung zu"
Wolfgang Ludwig